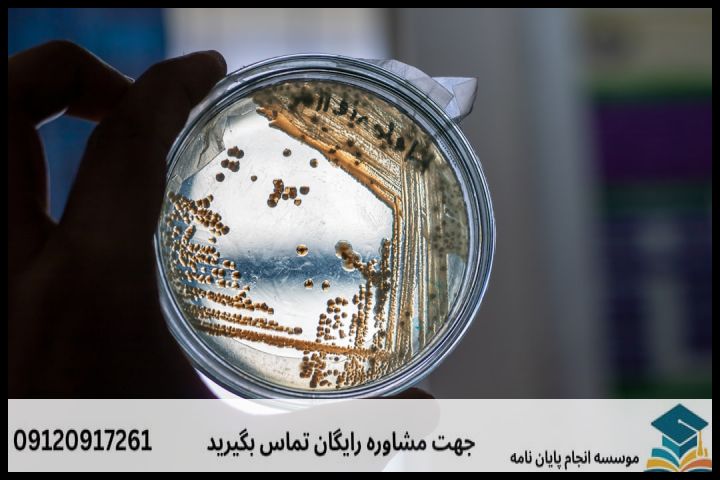

انجام پایان نامه شیمی تجزیه + مشاوره، نگارش و اصلاح [ارشد و دکتری]

****انجام پایان نامه شیمی تجزیه + مشاوره، نگارش و اصلاح [ارشد و دکتری]**** ****شیمی تجزیه: قلب تپنده علم و صنعت**** شیمی تجزیه، شاخهای حیاتی از علم شیمی است که به شناسایی و اندازهگیری اجزا یا آنالیتهای موجود در یک نمونه میپردازد. این حوزه با توسعه روشها و ابزارهای نوین، نقش بیبدیلی در صنایع مختلف از […]
انجام پایان نامه شیمی آلی + مشاوره، نگارش و اصلاح [ارشد و دکتری]

انجام پایان نامه شیمی آلی + مشاوره، نگارش و اصلاح [ارشد و دکتری] نگارش پایاننامه شیمی آلی در مقاطع کارشناسی ارشد و دکتری، نقطهی اوج سالها تحصیل و پژوهش یک دانشجو است. این فرآیند نه تنها مستلزم دانش عمیق نظری و مهارتهای آزمایشگاهی، بلکه نیازمند برنامهریزی دقیق، نگارش اصولی و توانایی تحلیل و تفسیر دادههاست. […]
انجام پایان نامه زیست شناسی دریا + مشاوره، نگارش و اصلاح [ارشد و دکتری]

انجام پایان نامه زیست شناسی دریا + مشاوره، نگارش و اصلاح [ارشد و دکتری] مقدمه: اقیانوس بیکران دانش زیست شناسی دریا زیست شناسی دریا، مطالعه حیات در گستردهترین زیستگاه کره زمین، اقیانوسها، دریاها و بومسازگانهای ساحلی را شامل میشود. این رشته، گستره وسیعی از موضوعات، از میکروبهای اعماق اقیانوس گرفته تا پستانداران دریایی عظیمالجثه و […]
انجام پایان نامه زیست شناسی علوم جانوری + مشاوره، نگارش و اصلاح [ارشد و دکتری]

انجام پایان نامه زیست شناسی علوم جانوری + مشاوره، نگارش و اصلاح [ارشد و دکتری] پایاننامه در مقاطع کارشناسی ارشد و دکتری، نقطهی اوج سالها تحصیل و پژوهش در هر رشتهای است. برای دانشجویان زیستشناسی علوم جانوری، این مرحله از اهمیت دوچندانی برخوردار است، چرا که نه تنها نشاندهندهی تسلط بر مبانی نظری و عملی […]
انجام پایان نامه زیست شناسی علوم گیاهی + مشاوره، نگارش و اصلاح [ارشد و دکتری]

/* شروع کدهای CSS برای طراحی منحصر به فرد و ریسپانسیو این استایلها برای نمایش بهینه در انواع دستگاهها (موبایل، تبلت، لپتاپ، تلویزیون) تنظیم شدهاند و قابلیت کپی مستقیم در ویرایشگرهای بلوکی و کلاسیک را دارند. */ /* تنظیمات کلی کانتینر مقاله */ .article-container { font-family: ‘Tahoma’, ‘Arial’, sans-serif; /* فونتهای خوانا و رایج */ […]
انجام پایان نامه زیست شناسی بیوشیمی + مشاوره، نگارش و اصلاح [ارشد و دکتری]

“`html انجام پایان نامه زیست شناسی بیوشیمی + مشاوره، نگارش و اصلاح [ارشد و دکتری] مقدمهای بر جهان پایاننامههای بیوشیمی پایاننامه، به ویژه در مقاطع کارشناسی ارشد و دکتری، نقطه اوج تلاشهای علمی و پژوهشی یک دانشجو است. در رشته زیست شناسی بیوشیمی، این مسیر پیچیدگیها و ظرافتهای خاص خود را دارد. از انتخاب موضوعی […]
انجام پایان نامه زیست شناسی بیوتکنولوژی میکروبی + مشاوره، نگارش و اصلاح [ارشد و دکتری]
انجام پایان نامه زیست شناسی بیوتکنولوژی میکروبی + مشاوره، نگارش و اصلاح [ارشد و دکتری] پایاننامه، نگین تاج دوره تحصیلات تکمیلی است و در رشتههای حیاتی و پویایی چون زیستشناسی، بیوتکنولوژی و میکروبیولوژی، اهمیت دوچندانی پیدا میکند. این مسیر نه تنها عرصهای برای نمایش دانش و مهارتهای پژوهشی شماست، بلکه فرصتی بیبدیل برای مشارکت در […]
انجام پایان نامه زیست شناسی میکروبیولوژی + مشاوره، نگارش و اصلاح [ارشد و دکتری]

انجام پایان نامه زیست شناسی میکروبیولوژی + مشاوره، نگارش و اصلاح [ارشد و دکتری] رشته زیستشناسی میکروبیولوژی، با تمرکز بر مطالعه میکروارگانیسمها و نقش آنها در اکوسیستمها، سلامت و صنعت، یکی از حوزههای حیاتی علوم زیستی است. نگارش پایاننامه در مقاطع ارشد و دکتری این رشته، اوج فعالیت پژوهشی و نشاندهنده توانایی دانشجو در تولید […]
انجام پایان نامه زیست شناسی ژنتیک + مشاوره، نگارش و اصلاح [ارشد و دکتری]

انجام پایان نامه زیست شناسی ژنتیک + مشاوره، نگارش و اصلاح [ارشد و دکتری] رشته زیستشناسی ژنتیک، ستون فقرات درک ما از حیات، تکامل و بیماریها است. انجام پایاننامه در این حوزه، دروازهای به سوی اکتشافات نوین و پیشرفتهای علمی به شمار میرود. با این حال، پیچیدگیهای ذاتی مباحث ژنتیک، حجم بالای دادهها و نیاز […]
انجام پایان نامه زیست شناسی سلولی و مولکولی + مشاوره، نگارش و اصلاح [ارشد و دکتری]

انجام پایان نامه زیست شناسی سلولی و مولکولی + مشاوره، نگارش و اصلاح [ارشد و دکتری] زیست شناسی سلولی و مولکولی، رشتهای پویا و حیاتی است که در قلب علوم زیستی و پزشکی مدرن جای دارد. از کشف ساختارهای بنیادین سلول گرفته تا رمزگشایی از پیچیدگیهای ژنتیکی و مکانیزمهای بیماریها، این حوزه پیوسته در حال […]
